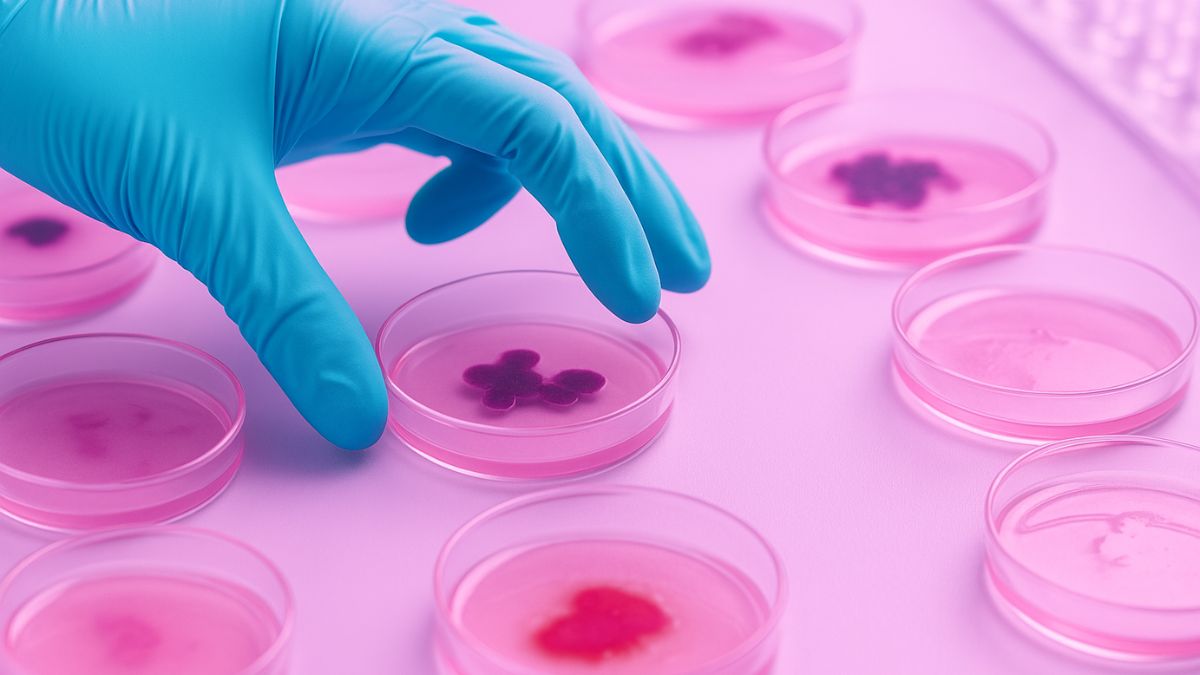
tendencias en medicina estética 2026

Tendencias emergentes en medicina estética para 2026: lo que todo profesional debe conocer
Tendencias emergentes en medicina estética para 2026: innovación, ética y futuro
La medicina estética vive un momento de transformación profunda. Cada año surgen nuevas tecnologías, materiales y protocolos que redefinen el concepto de belleza y bienestar. En Colombia, este cambio está liderado por profesionales formados bajo estándares internacionales, respaldados por instituciones como ACICME (Asociación Científica Colombiana de Medicina Estética), referente nacional en educación y actualización médica.
De cara al 2026, las tendencias apuntan hacia una estética más humana, tecnológica y sostenible. Estas son las claves que marcarán el futuro de la práctica estética profesional.
1. Biotecnología y tratamientos de nueva generación
La biotecnología aplicada a la medicina estética impulsará terapias no invasivas con resultados naturales y regenerativos. Veremos un aumento del uso de péptidos biomiméticos, nanocosmética terapéutica y biorevitalizadores celulares, enfocados en estimular los mecanismos de reparación natural de la piel. Además, los tratamientos con plasma rico en plaquetas (PRP) evolucionan hacia protocolos más precisos y efectivos.
2. Personalización con inteligencia artificial
La inteligencia artificial (IA) permite analizar en segundos el tipo de piel, nivel de envejecimiento y simetría facial, creando planes 100% personalizados. Con la integración de imágenes 3D, los pacientes podrán visualizar resultados antes del procedimiento, mejorando su confianza y la comunicación médico-paciente.
3. Medicina estética integral y bienestar
El nuevo enfoque se aleja del ideal superficial de belleza. La medicina estética integral incorpora nutrición, salud mental y bienestar físico. Los médicos estéticos trabajan junto a endocrinólogos, fisioterapeutas y psicólogos para crear programas de rejuvenecimiento global. ACICME fomenta esta visión multidisciplinaria en sus programas formativos.
4. Ética y sostenibilidad: pilares del futuro
Los pacientes buscan clínicas comprometidas con el medio ambiente y la ética profesional. La sostenibilidad se traduce en el uso de productos trazables, envases reciclables y prácticas médicas responsables. En este escenario, la certificación y respaldo de ACICME otorgan credibilidad y confianza, elementos cada vez más valorados en el sector.
5. Formación continua y congresos especializados
La actualización constante es clave para la excelencia. ACICME ofrece cursos, talleres y congresos internacionales que permiten a los médicos dominar las nuevas técnicas y regulaciones. Su Congreso Colombiano de Medicina Estética se consolida como el principal espacio de aprendizaje y networking científico del país.
6. Educación híbrida y práctica digital
La formación médica se adapta a un modelo híbrido que combina clases presenciales, módulos online y talleres prácticos. Esta modalidad facilita el acceso a profesionales de distintas regiones. Además, la digitalización permite ofrecer teleconsultas estéticas y seguimiento post-tratamiento mediante plataformas seguras.
7. Reputación digital y comunicación médica
El marketing médico ético gana relevancia. Las redes sociales son ahora espacios educativos donde los médicos informan, desmitifican y conectan con su comunidad. Mantener la transparencia, mostrar resultados reales y comunicar con ética fortalece la reputación profesional. La membresía en asociaciones científicas como ACICME refuerza esa credibilidad.
8. Tecnología y humanidad: el equilibrio perfecto
El futuro de la estética combina precisión tecnológica con empatía. Los pacientes no buscan solo rejuvenecer, sino sentirse mejor consigo mismos. La verdadera innovación radica en unir ciencia, sensibilidad y propósito. Esa es la medicina estética que dominará el 2026.
Conclusión
La medicina estética avanza hacia un modelo basado en la ciencia, la ética y la educación continua. ACICME representa ese compromiso en Colombia, formando profesionales preparados para los desafíos del futuro.
👉 Visita ACICME.com.co para conocer sus próximos cursos, congresos y programas de formación en medicina estética.